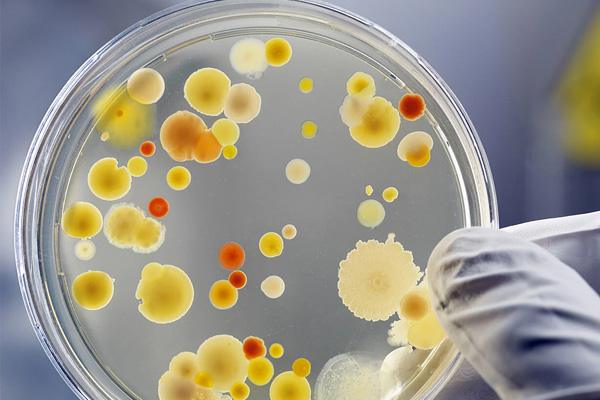
MICROBIOLOGY MICROBIOLOGY

MICROBIOLOGY
A major contribution of microbiology has been learning the role of microbes in disease. It is now known that bacteria cause diseases such as plague, tuberculosis, and anthrax; protozoans cause diseases such as malaria, sleeping sickness, and toxoplasmosis; fungi cause diseases such as ringworm, candidiasis, and histoplasmosis; and viruses cause diseases such as influenza and yellow fever. Host-parasite relationships have been worked out, such as understanding that Plasmodium (cause of malaria) utilizes Anopheles mosquitoes in transmission; some Trypanosoma species (cause of African trypanosomiasis, or sleeping sickness, and Chagas disease, or South American trypanosomiasis) utilize the tsetse fly or conenose bugs; and Leishmania (cause of leishmania) is carried by sand flies. Because of these findings, microbiologists have been able to develop antibiotics and vaccines, and the public has become aware of the importance of hygiene and means to avoid insect vectors (repellents, mosquito nets, etc.).